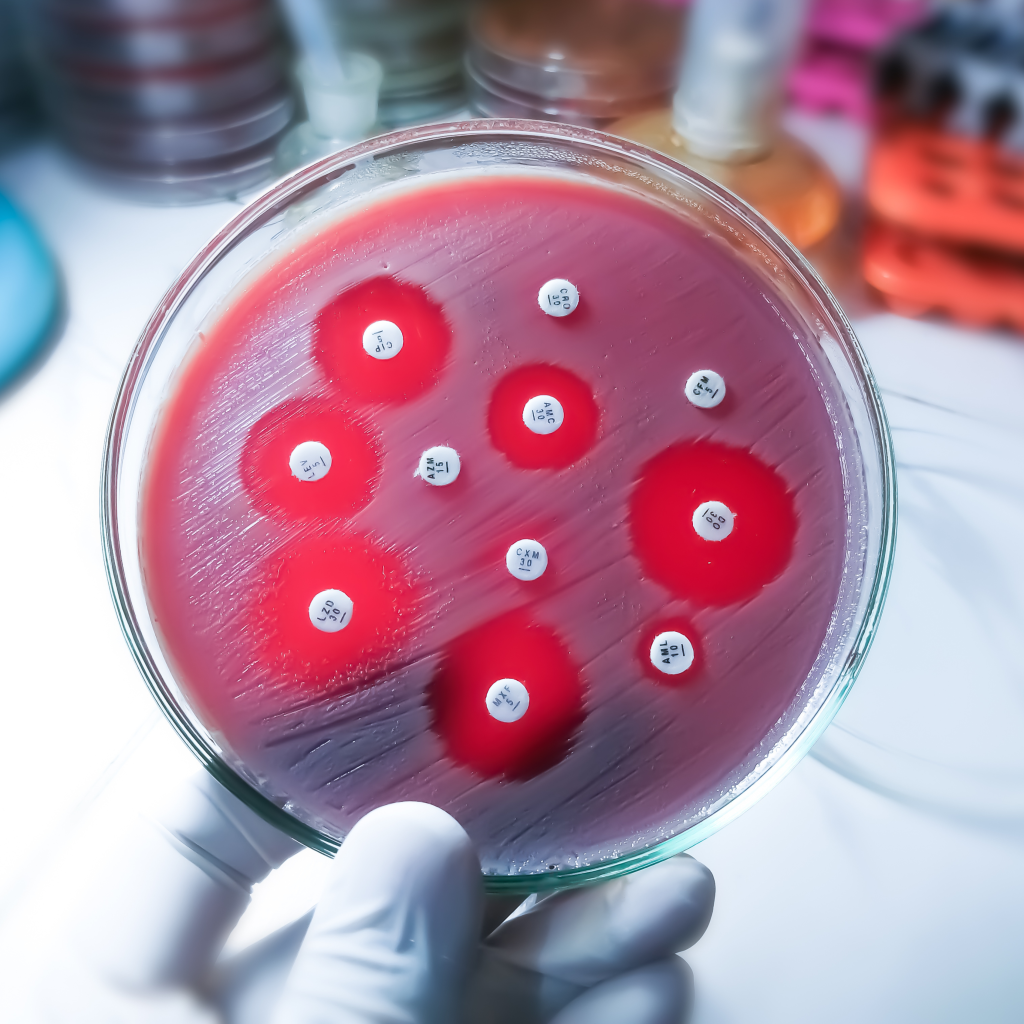

Bringing content and stories to life.
Leveraging more than 25 years of experience, and his unique storytelling abilities, Sean brings a range of content and stories to life. Approaching each assignment and project with the same level of enthusiasm, he works with clients to develop the highest quality content possible, while informing and inspiring readers.

Recently published content by Sean Tarry Writes:

Amachris: 20 years of delivering world-class retail spaces
Maintaining a focus on the customer and core competencies and beliefs, allows leading Canadian retail construction build specialists to continue growing.
April 2024

Preparing to combat the next global pandemic
Scientists and researchers all across the country, and the world, are working diligently to protect populations from harmful impacts of the next deadly virus.
April 2024

VIDO-InterVac: helping to build a healthier world
Canadian vaccine and infectious disease organization, and centre for pandemic research, continuously working to protect communities all over the world.
April 2024

Fighting superbugs with predictive computation
By harnessing the power of artificial intelligence, Canadian researchers have managed to target a potential treatment for a drug-resistant bacteria.
January 2024

Slow economy and cautious consumer increasing pressure on Canadian grocers
A combination of reduced consumer food budgets and escalating costs requiring grocers across the country to adjust in order to remain successful.
April 2024
Preventing the spread of antibiotic-resistant pathogens
Dr. Ronnie Banerjee and their team may have recently developed a new means by which to combat against the spread of nasty pathogens.
April 2024

Developing a better understanding of bacterial resistance
Scientists from the University of Guelph are working to study the ways in which several infectious bacteria build a protective sugar-based barrier that helps cloak their cells.
April 2024

Are we at the artificial intelligence tipping point?
As technologies continue to evolve and their capabilities expand, it seems only a matter of time until the real impacts of AI begin to take hold.
January 2024

The state of Canadian ecommerce: it’s time to get better in the face of adversity
Friction within an oversaturated online market is leading to the need for retailers everywhere to truly differentiate themselves from competitors.
April 2024

The Burrows Lab: disarming bacterial antimicrobial resistance
Work being conducted at McMaster University laboratory aims to combat the most deadly antimicrobial resistance in bacteria.
April 2024

Cult Food Science: pioneering a new era of food production
Vancouver-based foodtech company leading the cellular agriculture charge through innovation and a desire to change the perception of food production.
April 2024

Transforming the current and future state of gynecological care
Canadian startup company advancing gynecological research and work by addressing age-old pelvic floor disorders in women.
January 2024

Empower Health: helping to close gaps in the healthcare system
Leveraging the power of artificial intelligence, healthcare services can be defragmented to better connect patients with professionals.
January 2024

Inverte: turning food waste upsidedown
Tracking food portions in real-time to better manage food and labour costs and enhance operational consistency.
January 2024

The rise of AI-enabled retail experiences
The next 12-plus months will present retailers with boundless opportunities to get closer to consumers and enhance their businesses.
December 2023

Entering the data-driven future of the spa business
Mountains of information, its careful curation, and the creation of datasets could lead to revolutionary results for spa operators.
December 2023

The heart of the matter
Critical funding helping scientists and researchers advance their studies of rare genetic diseases impacting humans.
October 2023

Decarbonizing Canada’s food supply chain
Goals to reduce carbon footprint from operations are influencing a shift in supply chain strategy among Canada’s food and beverage industries.
October 2023

Keeping it real
Ensuring the use of organic, sustainable and environmentally-friendly products within the spa can help broaden customer appeal.
September 2023

Creating curated customer experiences
How 100 Fountain Spa manages to maintain such a high standard of excellence within the competitive spa industry.
September 2023

Facilitating innovation and solutions through science and technology
The Saskatchewan Research Council helping industries solve technology problems and seize economic opportunities.
July 2023

Fostering Canadian food sector innovation and growth
Canadian Food Innovation Network intensifying its offering with appointment of Alex Barlow as VP of Programs.
July 2023

Slowing online sales ahead of big digital opportunities
Canadian e-commerce performance lagging, but boosted by the promise of technological advancements
June 2023

Providing an authentic experience for your guests
Avoiding the use of counterfeit and fraudulent product in order to maintain the integrity of the industry.
June 2023

The artificial intelligence and machine learning revolution
The ten most influential ways in which artificial intelligence and machine learning are being leveraged to advance medical research.
January 2024

Top consumer tastes for 2024 revealed
Report reveals predictions for the trends and flavours that will whet the most appetites over the course of the next year.
January 2024

The Dol-as Spa experience
Finding rest, relaxation and an escape from stresses within authentic East Coast personalized hospitality.
December 2023

Building tech-enabled spa experiences guests crave
The spa industry is currently evolving with advanced technologies in order to remain relevant in the digital age.
December 2023

Engineering the future of drug discovery
VoxCell BioInnovations” revolutionary 3D bioprinting technology helping to optimize the drug development process.
October 2023

Protecting the retail experience
GardaWorld helping to ensure a safe and secure environment for the staff, guests and assets of retail organizations everywhere to enjoy.
September 2023

Maintaining a strong core
Focusing on the customers and offerings that are central to the business to enable future growth and success.
September 2023

Pick of the crop
MustGrow Biologics Corp’s cutting-edge plant-based technology platform is revolutionizing global crop production.
July 2023

Genecis Bioindustries: getting the most out of waste
Toronto-based biotechnology company turning organic waste into sustainable, biodegradable materials.
July 2023

Exploring the future state of global food systems
Report identifies the most significant trends impacting the world’s food systems today, and tomorrow.
July 2023

2023 Aspire Spa & Wellness Soiree honours industry excellence
Celebrating excellence and innovation within the Canadian spa industry at Leading Spas of Canada’s annual awards gala.
June 2023

Roundtable discussion: overcoming today’s staffing challenges
Panelists weigh in on issues impacting spas in their pursuit of top talent and the things they can do to retain their expertise.
June 2023

Croptracker: managing crop growth in the digital age
Cutting-edge farm management software helping fruit and vegetable growers enhance productivity and improve traceability.
January 2024

Retail trends 2024
Identifying the most significant factors presenting retail challenges and opportunities throughout the coming year.
December 2023

Looking and feeling great
Report unveils the top trends, treatments and innovations for spa owners to keep their eyes on in 2024.
December 2023

In the best of hands: expert staff the key to Dol-as Spa’s success
Joann Patriquin, Spa Director, Dol-ás Spa at Fox Harb’r Resort, explains how expert staff are the key to its success.
December 2023

What’s being printed?
A list of the growing number of clinical applications for 3D bioprinting technology, and their life-saving potential.
October 2023

Soothing the body, mind and soul
100 Fountain Spa in Niagara-on-the-Lake offers its visitors an opportunity to escape into a resort-like environment amid the beauty of wine country.
September 2023

The Feng Shui of spa tranquility
Leveraging the aspects of an ancient practice can help spa owners elevate their businesses and enhance the experiences they offer..
September 2023

Getting ahead of Parkinson’s disease
New scientific research uncovers an early alarm system for patients at high risk of developing the degenerative brain disorder.
July 2023

Biome-friendly ingredients for a healthier future
Phycus Biotechnologies Inc. developing alternatives to toxic cosmetics ingredients in hopes of creating a healthier tomorrow.
July 2023

A unified retail experience for greater performance
Creativity, innovation, technological advancement, and retail intuition leading to industry improvements and enhancements.
June 2023

Maintaining a legacy of care at Le Monastere des Augustines
Leveraging its rich monastic history and tradition, vintage Quebec spa offers visitors a unique stay like no other.
June 2023

The science behind your favourite spa treatments
Every great spa treatment offers those receiving them with incredible benefits, and are all rooted in the science of our anatomies.
June 2023